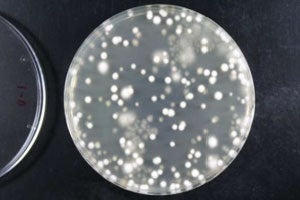
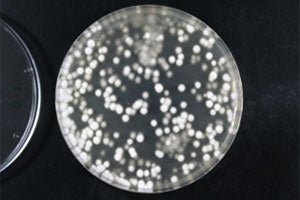

株式会社ユーピー
電解強酸性水で白癬菌(水虫の原因菌)10秒以内の不活性化を確認
2026年03月02日
株式会社ユーピー
研究機関・大学研究室様への実験機の提供、貸与を開始
1991年より電解水生成器を専門的に取り扱っている株式会社ユーピー(神奈川県横浜市 代表:橋本 克之)は、昨年末、自社製品の『トータル電解水生成器 次亜クアトロ』で生成した電解強酸性水と電解高濃度次亜水を用いた白癬菌の不活性試験を、第三者機関である地方独立行政法人 神奈川県立産業技術総合研究所にて実施しました。

トータル電解水生成器 次亜クアトロ
試験内容は白癬菌(水虫の原因菌)に対する不活性試験で、電解強酸性水(pH2.7以下、次亜塩素酸濃度40ppm前後)および電解高濃度次亜水(pH5.5~6.0、次亜塩素酸濃度500ppm前後)2種類の電解機能水を用い、作用時間10秒・30秒・60秒で評価した結果、両試験水において10秒以内に白癬菌の不活性化が確認されたとの報告を受けました。
白癬菌(水虫の原因菌)への不活性試験
不活性試験 10秒後

滅菌水

強酸性水

滅菌水

高濃度次亜水 500ppm前後
電解次亜塩素酸水による白癬菌外の不活性時間

殺菌効果または不活化効果: ◎(即効)>○>△>▲>×(無効)
引用:一般財団法人機能水研究振興財団「機能水とは」
なお、公益社団法人日本皮膚科学会の全国疫学調査によれば、足白癬が増え始める5月の時点で、約5人に1人に足白癬が、約10人に1人に爪白癬がみられるといいます。足白癬は夏季に増加し、冬季に減少する傾向があることから、同調査を7月に実施した場合には、足白癬の割合(有病率)はさらに高まることが想定されます。
一方、爪白癬は季節的変動が明らかではなく、日本国内では1,000万人以上の爪白癬患者が常在し、年齢の上昇に伴い頻度(有病率)が高まり、90歳以上の高齢男性では5割を超えるとの報告もあります。
本不活性試験および全国疫学調査の結果を受け、当社では身近な感染症「水虫」への対策に向けて、当社製品『トータル電解水生成器 次亜クアトロ』を用いた臨床研究および開発研究等の実施を希望される研究機関・大学研究室様を対象に、実験機の提供および貸与の募集を開始いたします。
現在研究を実施中の方、または今後研究調査を開始される研究者の皆様からのお申し出をお待ちしております。
■ 製品情報
トータル電解水生成器 次亜クアトロ
詳細ページ:https://www.jousui.com/business/product/quattro/
■ 本件に関するお問い合わせ先
株式会社ユーピー 担当:橋本
241-0816
神奈川県横浜市旭区笹野台1-44-5
Tel. 0120-367-255
info@up-x.com
https://www.jousui.com/business/
企業プレスリリース詳細へ
PR TIMESトップへ
研究機関・大学研究室様への実験機の提供、貸与を開始
1991年より電解水生成器を専門的に取り扱っている株式会社ユーピー(神奈川県横浜市 代表:橋本 克之)は、昨年末、自社製品の『トータル電解水生成器 次亜クアトロ』で生成した電解強酸性水と電解高濃度次亜水を用いた白癬菌の不活性試験を、第三者機関である地方独立行政法人 神奈川県立産業技術総合研究所にて実施しました。

トータル電解水生成器 次亜クアトロ
試験内容は白癬菌(水虫の原因菌)に対する不活性試験で、電解強酸性水(pH2.7以下、次亜塩素酸濃度40ppm前後)および電解高濃度次亜水(pH5.5~6.0、次亜塩素酸濃度500ppm前後)2種類の電解機能水を用い、作用時間10秒・30秒・60秒で評価した結果、両試験水において10秒以内に白癬菌の不活性化が確認されたとの報告を受けました。
白癬菌(水虫の原因菌)への不活性試験
不活性試験 10秒後
滅菌水

強酸性水
滅菌水

高濃度次亜水 500ppm前後
電解次亜塩素酸水による白癬菌外の不活性時間

殺菌効果または不活化効果: ◎(即効)>○>△>▲>×(無効)
引用:一般財団法人機能水研究振興財団「機能水とは」
なお、公益社団法人日本皮膚科学会の全国疫学調査によれば、足白癬が増え始める5月の時点で、約5人に1人に足白癬が、約10人に1人に爪白癬がみられるといいます。足白癬は夏季に増加し、冬季に減少する傾向があることから、同調査を7月に実施した場合には、足白癬の割合(有病率)はさらに高まることが想定されます。
一方、爪白癬は季節的変動が明らかではなく、日本国内では1,000万人以上の爪白癬患者が常在し、年齢の上昇に伴い頻度(有病率)が高まり、90歳以上の高齢男性では5割を超えるとの報告もあります。
本不活性試験および全国疫学調査の結果を受け、当社では身近な感染症「水虫」への対策に向けて、当社製品『トータル電解水生成器 次亜クアトロ』を用いた臨床研究および開発研究等の実施を希望される研究機関・大学研究室様を対象に、実験機の提供および貸与の募集を開始いたします。
現在研究を実施中の方、または今後研究調査を開始される研究者の皆様からのお申し出をお待ちしております。
■ 製品情報
トータル電解水生成器 次亜クアトロ
詳細ページ:https://www.jousui.com/business/product/quattro/
■ 本件に関するお問い合わせ先
株式会社ユーピー 担当:橋本
241-0816
神奈川県横浜市旭区笹野台1-44-5
Tel. 0120-367-255
info@up-x.com
https://www.jousui.com/business/
企業プレスリリース詳細へ
PR TIMESトップへ
